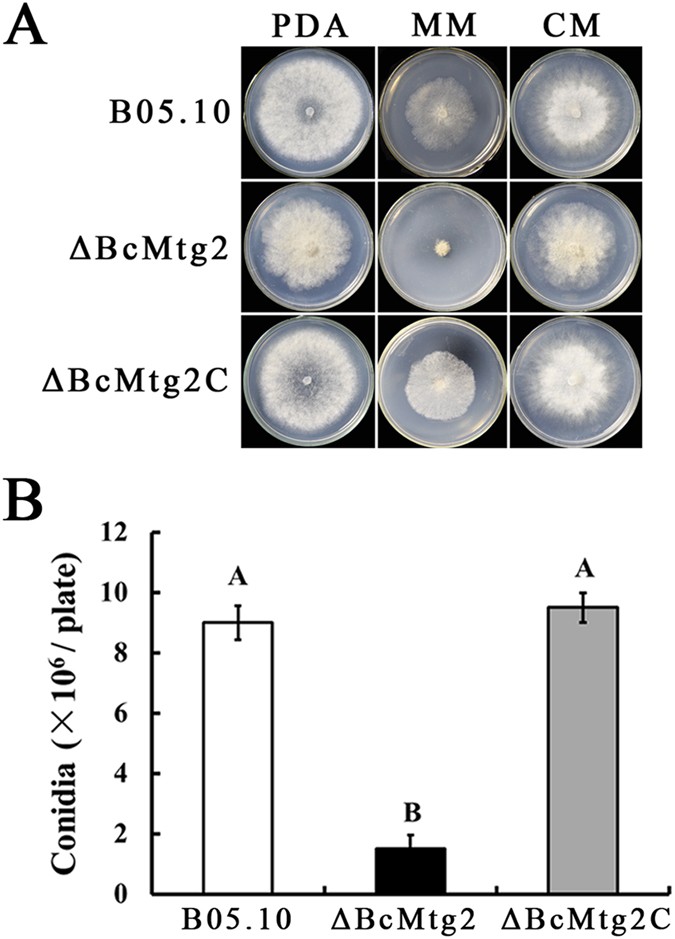
figure 1

Abstract
In Saccharomyces cerevisiae, the Mtg2 gene encodes the Obg protein, which has an important function in assembling ribosomal subunits. However, little is known about the role of the Obg GTPase in filamentous fungi. In this study, we identified an Mtg2 ortholog, BcMtg2, in B. cinerea. The BcMtg2 deletion mutant showed a defect in spore production, conidial germination and sclerotial formation. Additionally, the mutant increased sensitivity to various environmental stresses. The BcMtg2 mutant exhibited dramatically decreased virulence on host plant tissues. BcMtg2 mutant showed increased sensitivity to osmotic and oxidative stresses and to Congo red (cell wall stress agent). In the yeast complement assay, growth defects of yeast BY4741ΔMTG2 mutant were partly restored by genetic complementation of BcMtg2 under these environmental stresses. Additionally, compared with the parental strain and complement strain, the BcMtg2 deletion mutant displayed a minor glycerol response to osmosis stress. These defective phenotypes were recovered in the complement strain ΔBcMtg2C, which was created by adding the wild-type BcMtg2 gene to the ΔBcMtg2 mutant. The results of this study indicate that BcMtg2 has a necessary role in asexual development, environmental stress response and pathogenicity in B. cinerea.
Similar content being viewed by others
Introduction
GTPases have significant roles in many cell processes, including cell signaling, protein modification, cell reproduction, membrane permeability and cell growth. Furthermore, GTPases are conserved in many types of organisms, including eukaryotes and prokaryotes1,2,3,4. All organisms possess many conserved GTPases that are predicted to play roles in transcription5. Several of these GTPases have direct evidence for a role in ribosome function6,7,8. Prokaryotic GTPases include Era and Obg. The Era GTPase deletion mutant showed a decreased size of the ppGpp pool, had disturbed carbon metabolism and presented a polykaryon phenotype9,10,11. The Obg GTPase is another member of the prokaryotic GTPase superfamily. The Obg subfamily of GTPases has been sequenced and identified in all organisms to date12. Obg GTPase proteins have a conserved GTP-binding domain, indicating that they generate a general pattern of modification. Bacterial and mitochondrial Obg GTPase proteins may be orthologous because they are conserved throughout their protein lengths compared with other eukaryotic Obg GTPase proteins that have significantly distinct amino acid sequences except for the GTP-binding domain12. Previous studies have shown that various organisms have an Obg GTPase G-2 modification, including bacteria and humans1. In Bacillus subtilis, Obg GTPase proteins play an important role in original spore formation and vegetative growth13,14. In addition, previous research has shown that Obg GTPase proteins have an important function in regulating the σB transcription factor in B. subtilis15. Furthermore, in Escherichia coli, ObgE is necessary for chromosome disjunction1. In Caulobacter crescentus, the Obg family gene CgtA is essential for growth16. In Arabidopsis thaliana, the AtObgC, a homolog of the bacterial Obg GTPase gene, has an indispensible function in the synthesis of chloroplast proteins in early embryo development17. In Saccharomyces cerevisiae, each characteristic Obg GTPase protein seems to have a particular effect on ribosome function. The fourth S. cerevisiae mitochondrial Obg GTPase protein is encoded by YHR168W and is hereafter named Mtg2 for mitochondrial GTPase 212. Mtg2 is indispensable for assembling the yeast mitochondrial ribosome18. Mtg2 deletion mutations have defects in mitochondrial translation, which indicates that Mtg2 plays an important role in mitochondrial ribosome function12. The protein encoded by the gene is a member of the Obg GTPase family, which plays a role in ribosomal assembly via binding the majority ribosomal subunit19. Thus, these studies have indicated that various Obg GTP proteins perform different functions in specific organisms. In our study, we analyzed the roles of the Mtg2 homologous gene BcMtg2 in Botrytis cinerea, this knowledge provides information for designing novel fungicides to control gray mold caused by B. cinerea and exploring the function of BcMtg2 in B. cinerea.
B. cinerea causes gray mold which is a widespread and serious plant disease throughout the world20. Most plant organs, including leaves, shoots, bulb, flowers and root tubers, are sensitive to B. cinerea infection. In varied environmental conditions, B. cinerea uses various patterns to infect its multiple hosts. In addition, B. cinerea can survive as conidia, sclerotia and mycelia for a period of time21. Therefore, controlling gray mold presents many challenges. Understanding the biology and host-pathogen interactions of B. cinerea is valuable for the discovery of an efficient strategy to control gray mold. A whole-genome search uncovered that B. cinerea an orthologue of Mtg2 (hereafter named BcMgt2). Base on the previous research, we hypothesized that BcMtg2 might own important effect on vegetative differentiation and virulence in B. cinerea. To clarify this hypothesis, the major objective of this study was to analyse the genetic, biological and biochemical function of BcMtg2 using target gene deletion strategy. Our study revealed that BcMtg2 plays significant role in regulating the asexual reproduction, vegetative growth, various stresses response and virulence in B. cinerea.
Results
Identification of the BcMtg2 gene
Using the amino acid sequence of the S. cerevisiae Mtg2 protein, BcMtg2 was identified in B. cinerea using a BLASTP search in the Botrytis cinerea genome database (http://www.broad.mit.edu). The nucleotide sequence of BcMtg2 is 1653 bp in size. The protein encoded by BcMtg2 contains 550 amino acids. The predicted amino acid sequence indicated no introns in BcMtg2. An analysis of domains in the BcMtg2 protein by SMART showed that BcMtg2 includes two conserved domains: a Mg2+/GTP binding site in the N-terminus and a switch region in the C-terminus (Fig. S1).
BcMtg2 regulates vegetative growth and asexual reproduction in B. cinerea
On either complete medium (CM) or potato dextrose agar medium (PDA), the mycelial growth rate of the BcMtg2 deletion mutant (ΔBcMtg2) was similar to the parental strain B05.10 and the complement strain ΔBcMtg2C. However, on minimal medium (MM), ΔBcMtg2 grew more slowly than the wild-type strain B05.10 and the complement strain ΔBcMtg2C (Fig. 1A). In conidiation assay, ΔBcMtg2 produced significantly fewer conidia than B05.10 and ΔBcMtg2C on PDA plate cultivated for 10 days (Fig. 1B). These results showed that BcMtg2 was involved in conidiation in B. cinerea. The germination rate of conidia in ΔBcMtg2 was reduced by 56%, compared with B05.10 and ΔBcMtg2C incubated for 15 h on Water-Agar medium (Fig. 2A). In addition, the germ tubes of the BcMtg2 deletion mutant were malformed (Fig. 2B). These results showed that BcMtg2 had an important role in mycelia growth and asexual reproduction in B. cinerea.
Function of BcMtg2 on Botrytis cinerea growth and conidiation.
(A) B05.10, ΔBcMtg2 and ΔBcMtg2C were grown on PDA, MM or CM at 25 °C for 3 days. (B) The number of conidia produced by each strain on PDA plates. Bars denote standard errors from three experiments. Values on the bars followed by the same letter are not significantly different at P = 0.05.
Effects of BcMtg2 deletion on conidial germination (A) Conidial germination rate of each strain after cultivated on Water-Agar media at 25 °C for 15 h. Bars denote standard errors from three experiments. Values on the bars followed by the same letter are not significantly different at P = 0.05. (B) Germinal tube morphology of each strain after incubated on Water-Agar media at 25 °C for 15 h. Conidia with short and abnormal germ tubes are indicated by arrows.
Sensitivity of B. cinerea response to various stresses is regulated by BcMtg2
To explore the role of BcMtg2 in B. cinerea response to multiple stresses, we measured the sensitivity of the wild-type strain B05.10, the BcMtg2 deletion mutant and the complemented strain ΔBcMtg2C to cell wall-damaging agents, osmotic stresses and oxidative pressure. Compared with the wild-type strain and the complemented strain, the sensitivity of ΔBcMtg2 to osmotic stress was significantly increased (Fig. 3A,B). Previous studies have indicated that glycerol content plays a significant role in the regulation of fungus response to osmotic stress22,23. Thus, we measured glycerol accumulation in the parental strain B05.10, the BcMtg2 deletion mutant and the complement strain ΔBcMtg2C. The result indicated that the parental strain B05.10, ΔBcMtg2 and ΔBcMtg2C generated little glycerol without osmotic stress. However, the glycerol content of the parental strain B05.10 and the complement strain ΔBcMtg2C were significantly increased compared with that of the BcMtg2 deletion mutant under osmotic stress conditions (Fig. 4A). Moreover, the previous study shown that the histidine kinase, BcBoS1 and the mitogen-activated protein kinase, BcSAK1 affect the sensitivity of B. cinerea responses to osmotic pressure24. The real-time PCR analysis showed that the transcription levels of the two genes were significantly decreased in ΔBcMtg2 compared with that in B05.10 and ΔBcMtg2C under osmotic stress conditions (Fig. 4B). In addition, compared with B05.10 and ΔBcMtg2C, ΔBcMtg2 presented increased sensitivity to the cell-damaging agent (Congo red) and to oxidative pressure (Fig. 3A,B). Previous studies had shown that Mkk1 and Gls2 were core component genes of cell wall completion in S. cerevisiae25. To understand the function of BcMtg2 in cell wall completion in B. cinerea, the transcription levels of BcMkk1 and BcGls2 in each strain were analyzed. Compared with the parental strain B05.10 and the complement strain ΔBcMtg2C, the expression levels of the two genes were significantly decreased in ΔBcMtg2 in response to Congo red (Fig. 4B), indicating that BcMtg2 involved in various environmental stress response in B. cinerea.
Sensitivity of B05.10, ΔBcMtg2 and ΔBcMtg2C to multiple stress.
(A) Comparisons were performed on PDA medium modified with Congo red, caffeine, NaCl, KCl, paraquat and H2O2 at the content indicated in the figure. (B) Inhibition of mycelial growth was analyzed after each strain was incubated for 3 days on PDA supplement with different compound as described in the figure. Bars denote standard errors from three experiments. Values on the bars followed by the same letter are not significantly different at P = 0.05.
(A) Glycerol content in mycelia of B05.10, ΔBcMtg2 and ΔBcMtg2C. Bars denote standard errors from three repeated experiments. (B) Expression levels of osmotic stress relation genes (BcBoS1, BcSAK1) and cell wall relation genes (BcMkk1 and BcGls2) in each strain. RNA samples were isolated from mycelia treated with NaCl (1.0 M) and Congo red (0.3 mg ml−1) for 2 h respectively. Bars denote standard errors from three repeated experiments.
BcMtg2 is involved in the sensitivity of B. cinerea response to cell wall lyase
The BcMtg2 deletion mutant exhibited increased sensitivity to a cell wall-damaging factor (Congo red). To further understand the role of BcMtg2 in cell wall integrity (CWI), we analyzed the sensitivity of ΔBcMtg2 to cell wall lyase. 0.1 g fresh mycelia of each strain was incubated with 15 mL 1.5% lyases buffer (0.6 M KCl, 50 mM CaCl2) at 30 °C for 45 min. Then, the amount of protoplast was counted with a hemocytometer. The result showed that ΔBcMtg2 mycelia were well digested and released significantly more protoplasts than the parental strain B05.10 and the complement strain ΔBcMtg2C (Fig. 5A,B), indicating that the BcMtg2 plays an important role in regulating CWI of B. cinerea.
Impact of BcMtg2 deletion on cell wall lyase sensitivity and sclerotial formation.
(A) Comparison of protoplast among B05.10, ΔBcMtg2 and ΔBcMtg2C After mycelia incubated at 30 °C for 45 min in 1.5% lyase buffer. (B) The number of protoplast release by each strain on lyase buffer. Bars in each column denote the standard errors of three experiments. Values on the bars followed by the same letter are not significantly different at P = 0.05. (C) Comparison of sclerotia formation among B05.10, ΔBcMtg2 and ΔBcMtg2C after cultivated on CM and PDA medium for 4 weeks at 25 °C in darkness. (D) The number of sclerotia was counted on both CM and PDA. Bars denote standard errors from three experiments. Values on the bars followed by the same letter are not significantly different at P = 0.05.
Effects of BcMtg2 deletion on sclerotia formation
To investigate the function of BcMtg2 in sclerotia development in B. cinerea, strains were cultivated in the dark for 4 weeks. ΔBcMtg2 produced significantly fewer sclerotia than B05.10 and ΔBcMtg2C on CM medium. In addition, B05.10 and ΔBcMtg2C produced vast sclerotia, while the BcMtg2 deletion mutant did not produce any sclerotia on PDA medium (Fig. 5C,D). These results indicated that BcMtg2 had an important effect on sclerotial formation in B. cinerea.
BcMtg2 is required for the virulence of B. cinerea
To investigate the involvement of BcMtg2 in virulence, the ability of the strain to infect various plant organisms was evaluated. As indicated in Fig. 6, ΔBcMtg2 caused significantly smaller disease spots than the parental strain B05.10 and the complement strain ΔBcMtg2C on wounded strawberry, grape, tomato and apple fruits, after 72 h of inoculation. Moreover, on wounded tomato leaves and strawberry leaves ΔBcMtg2 also caused obviously smaller disease spots than B05.10 and ΔBcMtg2C after 60 h of inoculation (Fig. 7A–C). These results indicated that BcMtg2 owned significant effect on the virulence in B. cinerea.
Virulence analysis on plant fruit, following inoculation with the parental strain B05.10, ΔBcMtg2 and ΔBcMtg2C.
Agar plugs were used as negative controls (CK). (A) Disease symptoms on wounded strawberry fruits after 72 h inoculation (h.p.i.), (B) wounded grape fruits 72 h.p.i, (C) wounded tomato fruits wounded 72 h.p.i, (D) wounded apple fruits 72 h.p.i. (E) Diameter of disease lesion on various fruit. Bars denote the standard errors of four repeated experiments. Values on the bars followed by the same letter are not significantly different at P = 0.05.
Virulence assays of each strain on plant leaf and complementation of the S. cerevisiae MTG2 mutant with BcMtg2.
(A) Disease symptoms on wounded tomato leaves 60 h after inoculation (h.p.i.). (B) Disease symptoms on wounded strawberry leaves 60 h after inoculation (h.p.i.). (C) Diameter of disease lesion on various plant leaf. Bars denote the standard errors of four repeated experiments. Values on the bars followed by the same letter are not significantly different at P = 0.05. (D) Serial dilutions of cell suspensions of each strain were spotted onto YPRG plates including no inhibitor (CK), H2O2, NaCl and Congo red (CR). The growth of each strain on the plates was examined after yeast cells had been cultivated at 30 °C for 4 days.
Complementation of yeast Mtg2 deletion mutants with BcMtg2
To further investigate the functions of BcMtg2, we determined whether BcMtg2 could complement the phenotype of the yeast Mtg2 mutant. Base on the BcMtg2 deletion mutant shown increased sensitivity to osmotic pressure (NaCl), cell wall inhibitor (Congo red) and oxidative stress (H2O2), we used the same environment stresses in to analyze the strains growth phenotype in the yeast complement assay. The parental strain and yeast Mtg2 mutant grew well on YEPG medium. However, compared with the parental strain and the complement strain, the Mtg2 mutant was obviously inhibited when the culture medium was modified with 4 mM H2O2 and 0.4 M NaCl. Additionally, the Mtg2 mutant and the complement strain were significantly hindered when the medium was modified with 130 mg ml−1 Congo red. These results indicated that the growth defects of Mtg2 were partially recovered by genetic complementation of the yeast Mtg2 mutant with BcMtg2 (Fig. 7D).
Discussion
Previous studies showed that the nuclear gene Mtg2 played an important role in the assembly of mitochondrial ribosomes in S. cerevisiae12,18. The protein is member of the Obg GTPase family19. The assembly of cytoplasmic ribosomes requires the coordinated action of assembly proteins26. These assembly factors include nucleases, ATP-dependent RNA helicases, modifying enzymes and a number of recently identified GTPases26,27,28,29. To investigate the function of BcMtg2 in B. cinerea, we analyzed the phenotype of the BcMtg2 deletion mutant. The previous study showed that a deletion mutant of the Rho4 GTPase gene was defective in vegetative growth and conidiation in Neurospora crassa30. In our study, the BcMtg2 deletion mutant exhibited a clear growth defect on MM medium (Fig. 1A). Moreover, compared with the parental strain and the complement strain, ΔBcMtg2 produced significantly fewer conidia and exhibited a lower conidia germination rate. The previous study indicated that the Ras small GTPase was involved in sclerotia development in Sclerotinia sclerotiorum31. The previous study showed that sclerotial development plays a significant role in the survival mechanism of B. cinerea in dying host organisms21. In our study, we found that ΔBcMtg2 produced significantly fewer sclerotia than the parental and complemented strains. In addition, in our study, we found that the BcMtg2 deletion mutant exhibited decreased virulence in various plant tissue. A similar phenotype was also observed in a Rho3 GTPase deletion mutant in B. cinerea32. These consequences indicated that GTPases may have a similar function in the regulation of asexual reproduction, vegetative growth, survival mechanism and virulence in plant pathogenic fungi.
In our study, the BcMtg2 deletion mutant exhibited significantly decreased virulence on host plant tissue. To date, the exact causes of the decreased pathogenicity of the BcMtg2 deletion mutant remain unclear, we inferred that the decreased pathogenicity of ΔBcMtg2 might be closely related to its reduced tolerance to various environmental stresses. First, the deletion of BcMtg2 leads to increased sensitivity of B. cinerea to cell wall-disrupting factors. The previous studies had shown that cell wall integrity is required for B. cinerea virulence33,34. Second, the BcMtg2 deletion mutant appeared to have increased sensitivity to oxidative stresses, which can be generated by a host plant during the host-fungus interaction35,36. However, B. cinerea possesses an effective ROS detoxification mechanism to address an oxidative burst37. The BcMtg2 deletion mutant may defect in ROS eliminated ability which resulted in the decreased pathogenicity. Third, a previous study showed that the fungal infection process might be related to osmotic stress38,39. The increased sensitivity of ΔBcMtg2 to osmotic stress may lead to defective virulence of B. cinerea on host plant tissue. Osmotic, oxidative stresses generated by host plant and cell wall integrity of B. cinerea significantly effect on the interaction of B. cinerea with host plant tissue33,34,35,36. To analyze the sensitivity of B. cinerea to osmotic, oxidative stresses and to Congo red which can enhance our understanding the reasons for the defect of BcMtg2 deletion mutant on virulence.
In our study, ΔBcMtg2 exhibited increased sensitivity to various environmental stresses compared with the parental and complemented strains. In the cell wall tolerance and osmotic pressure assays, we found that ΔBcMtg2 showed increased sensitivity to Congo red but not caffeine and increased sensitivity to Na but not K, respectively. This result may be caused by the fact that ΔBcMtg2 is selective between Congo red and caffeine and has the ability to adapt to different osmotic pressures generated by Na or K. This hypothesis needs to be explored in the future. Additionally, in yeast complement assay, we found the BcMtg2 was able to partially complement the phenotype defects of yeast Mtg2 mutant under the various environment stresses (NaCl, Congo red and H2O2). We deduced that the sequence difference between BcMtg2 and ScMtg2 leads to the biological function variation (Fig. S1). This assumption needs to be explore in the future research.
In conclusion, these results have indicated that the BcMtg2 protein possesses an important role in pathogenicity, vegetative growth, asexual reproduction and tolerance to multiple environmental stresses. Additionally, the BcMtg2 deletion mutant may influence the function of mitochondrial ribosomes to cause the different phenotypes we observed in our study. This assumption is being investigated in our lab. Based on the conclusions in our study, the Mtg2 protein played an important role in growth and development in B. cinerea. This protein was hopeful as a new potential antifungal drug target for the development of novel fungicide against gray mold caused by B. cinerea.
Methods
Strains, media and growth conditions
Botrytis cinerea strain B05.10 was isolated from a grape in California, USA used as the wild-type progenitor for the construction of the gene deletion mutant in this study32. The wild-type strain B05.10 and mutant strains were grown on PDA, MM or CM37 for the mycelial growth assays. For stress tests, strains were cultured on PDA modified with various supplements. Each plate was inoculated with a 5-mm diameter mycelial plug taken from the margin of a 3-day-old colony grown on PDA. In the yeast complement assay, all strains were grown on YEPG (1% yeast extract, 2% peptone, 1% galactose, 1% raffinose and 2% agar)37. The experiments were repeated three times independently.
Identification of BcMtg2 in B. cinerea
Based on the B. cinerea genome sequence database (http://www.broadinstitute.org/), BcMtg2 (BC1G_14222) was initially identified using the BLASTP algorithm and the Mtg2 protein from S. cerevisiae as the query. To determine the size and existence of introns, RNA was extracted from the hypha of the parental strain B05.10 using the RNAsimple Total RNA Kit (Tiangen Biotech. Co., Beijing, China) and used for first-strand cDNA synthesis with the PrimeScript RT Reagent Kit (TaKaRa, Dalian, China). PCR amplification of the cDNA was performed with the P1/P2 primer pair (Table S1). The resultant PCR product was purified, cloned and sequenced.
Generation of the BcMtg2 deletion mutant
The BcMtg2 deletion vector was constructed as described previously40. First, fragments 1.4 kb upstream and 1.3 kb downstream of BcMtg2 were amplified from the genomic DNA of the parental strain B05.10 using the primer pairs P3/P4 and P5/P6 (Table S1, Fig. S2A), respectively. The primer pair P7/P8 was used to amplify a 1.7-kb HPH cassette containing the hygromycin resistance gene and the Aspergillus nidulans trpC promoter41. Then, the three amplicons (upstream, HPH cassette and downstream) were fused using the primer pair P9/P1042 (Table S1, Fig. S2A). The resultant PCR product was gel purified with the AxyPreTP DNA Gel Extraction Kit (Axygen, USA) and used to transform protoplasts of the parental strain B05.10. Protoplasts were prepared and transformation was performed as described previously43.
Complementation of the BcMtg2 deletion mutant
To confirm that the defects of the BcMtg2 deletion mutant were caused by the gene deletion, the BcMtg2 deletion mutant was complemented with the entire BcMtg2 gene. The complemented BcMtg2 gene was amplified from the genome of the parental strain B05.10 using the P20/P21 primer pair, which included the 325-bp promoter sequence and 543-bp terminator region (Table S1). The resultant PCR product was cloned into the SmaI-XbaI site of pNEO to generate the complement vector, pNEO-BcMtg2-C. BcMtg2 in this vector was sequenced to verify that no errors were present in this sequence before the complement was transformed into the BcMtg2 deletion mutant. The transformation of ΔBcMtg2 with the complement vector was performed as previously described40.
Southern blot assay
Genomic DNA was extracted from B. cinerea using the previously described method44 and digested with XhoI. Southern blot analysis was performed with the 241-bp downstream fragment of BcMtg2 as a probe. The fragment was amplified from the B05.10 genome using the primer pair P23/P24 (Table S1, Fig. S2A). The probe was labeled with digoxigenin (DIG) using the High Prime DNA Labeling and Detection Starter Kit II (Roche Diagnostics).
Conidiation and sclerotial development analysis
To evaluate conidiation, mycelial plugs (5 mm in diameter) obtained from the margin of a 3-day-old colony were cultivated on PDA medium and grown at 25 °C for 8 days. Spores from each plate were acquired using sterile H2O. The suspension was filtered using three layers of gauze and the number of spores was calculated by a hemocytometer. To assay sclerotial production, 5-mm diameter mycelial plugs taken from the edge of a 3-day-old colony of each strain were inoculated onto PDA or CM and cultivated at 25 °C for 4 weeks in the dark. Then, the number of sclerotia was measured using a previously described method45. The experiment was repeated three times.
Assays for glycerol accumulation
To determine intracellular glycerol content, each strain was cultivated in YEPD medium (w/v, 1% peptone, 0.3% yeast extract, 2% glucose) for 2 days at 175 rpm at 25 °C in a shaker. After supplementing with 1.0 M NaCl and further incubation for 2 h, the mycelia of each strain were collected and ground in liquid nitrogen. Then, the mycelial powder (150 mg) was transferred to a 2-ml microcentrifuge tube containing 1 ml of glycerol extraction buffer (Applygen Technologies Inc., Beijing, China). After vortexing sufficiently for 1 min, the tubes were centrifuged at 6000× g for 10 min. Then, 10 μL of the resulting supernatant of each sample was transferred to a new tube and a 5-μL aliquot of each supernatant was mixed with 190 μL of glycerol determination buffer (Applygen Technologies Inc., Beijing, China). The coloration process was cultivated at 37 °C for 15 min. Then, the glycerol content was measured with a microplate reader (Molecular Devices Inc.) at 550 nm37. The experiment was independently repeated three times.
Quantitative real-time PCR
To extract total RNA, the mycelial plugs of the wild-type strain B05.10, the BcMtg2 deletion mutant or the complemented strain BcMtg2C were transferred to YEPD medium and cultured for 2 days at 25 °C in dark. Before the mycelia were harvested for RNA extraction, the culture was treated for 2 h with NaCl or Congo red at the concentrations indicated in the legend of Fig. 4. Total RNA was extracted from the mycelia of each strain using the RNeasy Kit (Tiangen Biotech. Co). Then, total RNA of each strain was purified using DNase to remove the contaminated DNA with Reagent Kit (TaKaRa) and 10 μg of each RNA sample was used for First Strand cDNA synthesis with the PrimeScript® RT Reagent Kit (TaKaRa). Real-time PCR was conducted in an ABI 7500 real-time system (Applied Biosystems) using SYBR Green I fluorescent dye detection. Amplification was conducted in a 20 μL volume containing 10 μL of iTaq™ Universal SYBR® Green Supermix (Bio-Rad Laboratories), 2 μL of the reverse transcription product and 1 μL each of the forward and reverse primers (Table S1). There were three replicates for each sample. The expression of the measured genes in each sample was normalized to the expression level of reference gene actin and relative changes in gene expression levels were analysed with the ABI 7500 SDS software (Applied Biosystems), which automatically sets the baseline. Data from three biological replicates were used to calculate the mean and standard deviation46. The experiment was repeated three times.
Determination of the sensitivity of ΔBcMtg2 to environmental stress
Mycelial growth assays were performed on PDA plates modified with the following elements: Congo red, caffeine, KCl, NaCl, H2O2, and paraquat at the concentrations shown in the figures. The percentage of inhibition of mycelial radial growth (PIMG) was calculated using the formula, PIMG = [(C − N)/(C − 5)] × 100, where C is the colony diameter of the untreated control and N is that of stress treatment47. The experiments were repeated twice.
Yeast complementation assays
The yeast wild type strain BY4741 and the MTG2 deletion mutant BY4741ΔMTG2 was provided by EUROSCARF (http://web.uni-frankfurt.de/fb15/mikro/euroscarf/). The full-length BcMtg2 cDNA was amplified from total RNA of B05.10 using the primer pair P35/P36 (Table S1). The PCR product was digested with BamHI and XbaI and cloned into the pYES2 vector (Invitrogen) and transformed into the yeast mutant BY4741ΔMTG2. Yeast transformants were selected on synthetic medium lacking uracil (Clontech). Additionally, the wild-type strain BY4741 and BY4741ΔMTG2 mutant transformed with empty pYES2 vector were used as controls. In the complementation assays, the yeast transformants were grown at 30 °C for 4 days on YPRG medium (1% yeast extract, 2% peptone, 1% galactose, 1% raffinose, 2% agar) modified with various stress agents including Congo red, NaCl and H2O2 at concentrations shown in figure legends. The experiments were repeated three times independently.
Plant tissue infection assays
Five-millimeter diameter mycelial plugs of 3-day-old colony grown on PDA were inoculated onto fully expanded leaves of tomato and strawberry plants and grape, tomato, strawberry and apple fruits. Inoculated plant tissues were cultivated at 25 °C with 16 h of daylight45. The disease lesions were recorded after the indicated times in the figure legends. The experiment was repeated four times.
Additional Information
How to cite this article: Shao, W. et al. BcMtg2 is required for multiple stress tolerance, vegetative development and virulence in Botrytis cinerea. Sci. Rep. 6, 28673; doi: 10.1038/srep28673 (2016).
References
Kobayashi, G., Moriya, S. & Wada, C. Deficiency of essential GTP-binding protein ObgE in Escherichia coli inhibits chromosome partition. Mol Microbiol 41, 37–51 (2001).
Bourne, H. R., Sanders, D. A. & McCormick, F. The GTPase superfamily: conserved structure and molecular mechanism. Nature 349, 117–127 (1991).
Cabrera-Vera, T. M. et al. Insights into G protein structure, function and regulation. Endocrine Rev 24, 765–781 (2003).
Caldon, C. E. & March, P. E. Function of the universally conserved bacterial GTPases. Curr Opin Microbiol 6, 135–139 (2003).
Leipe, D. D., Wolf, Y. I., Koonin, E. V. & Aravind, L. Classification and evolution of P-loop GTPases and related ATPases. J Mol Biol 317, 41–72 (2002).
Lin, B., Thayer, D. A. & Maddock, J. R. The Caulobacter crescentus CgtAC protein cosediments with the free 50S ribosomal subunit. J Bacteriol 186, 481–489 (2004).
Tan, J., Jakob, U. & Bardwell, J. C. Overexpression of two different GTPases rescues a null mutation in a heat-induced rRNA methyltransferase. J Bacteriol 184, 2692–2698 (2002).
Wout, P. et al. The Escherichia coli GTPase, CgtAE, cofractionates with the 50S ribosomal subunit and interacts with SpoT, a ppGpp synthetase/hydrolase. J Bacteriol 186, 5249–5257 (2004).
Britton, R. A., Powell, B. S., Court, D. L. & Lupski, J. R. Characterization of mutations affecting the Escherichia coli essential GTPase era that suppress two temperature-sensitive dnaG alleles. J Bacteriol 179, 4575–4582 (1997).
Gollop, N. & March, P. E. A GTP-binding protein (Era) has an essential role in growth rate and cell cycle control in Escherichia coli. J Bacteriol 173, 2265–2270 (1991).
Lerner, C. G. & Inouye, M. Pleiotropic changesresulting from depletion of Era, an essential GTP-binding protein in Escherichia coli. Mol Microbiol 5, 951–957 (1991).
Datta, K., Fuentes, J. L. & Maddock, J. R. The yeast GTPase Mtg2p is required for mitochondrial translation and partially suppresses an rRNA methyltransferase mutant, mrm2. Mol Biol Cell 16, 954–963 (2005).
Okamoto, S. & Ochi, K. An essential GTP-binding protein functions as a regulator for differentiation in Streptomyces coelicolor. Mol. Microbiol. 30, 107–119 (1998).
Trach, K. & Hoch, J. A. The Bacillus subtilis spo0B stage 0 sporulation operon encodes an essential GTPbinding protein. J Bacteriol 171, 1362–1371 (1989).
Welsh, K. M., Trach, K. A., Folger, C. & Hoch, J. A. Biochemical characterization of the essential GTP-binding protein Obg of Bacillus subtilis. J Bacteriol 176, 7161–7168 (1994).
Maddock, J., Bhatt, A., Koch, M. & Skidmore, J. Identification of an essential Caulobacter crescentus gene encoding member of the Obg family of GTP-binding proteins. J Bacteriol 179, 6426–6431 (1997).
Bang, W. Y. et al. AtObgC, a plant ortholog of bacterial Obg, is a chloroplasttargeting GTPase essential for early embryogenesis. Plant Mol Biol 71, 79–90 (2009).
Barrientos, A. et al. MTG1 codes for a conserved protein required for mitochondrial translation. Mol Biol Cell 14, 2292–2302 (2003).
Paul, M. F., Alushin, G. M., Barros, M. H., Rak, M. & Tzagoloff, A. The putative GTPase encoded by MTG3 functions in a novel pathway for regulating assembly of the small subunit of yeast mitochondrial ribosomes. J Biol Chem 287, 24346–24355 (2012).
Prins, T. W., Tudzynski, P. & Tiedemann, A. V. Infection strategies of Botrytis cinerea and related necrotrophic pathogens. In: Kronstad, J. W., ed. Fungal Pathology. Dordrecht, the Netherlands: Kluwer Academic Publishers 33–64 (2000).
Williamson, B., Tudzynski, B. & Van, Kan. A. J. A. Botrytis cinerea: the cause of grey mould disease. Mol Plant Pathol 5, 561–580 (2007).
Gustin, M. C., Albertyn, J., Alexander, M. & Davenport, K. MAP kinase pathways in the yeast Saccharomyces cerevisiae. Mol Biol Rev 62, 1264–1300 (1998).
Wojda, I., Alonso-Monge, R., Bebelman, J. P., Mager, W. H. & Siderius, M. Response to high osmotic conditions and elevated temperature in Saccharomyces cerevisiae is controlled by intracellular glycerol and involves coordinate activity of MAP kinase pathways. Microbiology 149, 1193–1204 (2003).
Liu, W., Leroux, P. & Fillinger, S. The HOG1-like MAP kinase Sak1 of Botrytis cinerea is negatively regulated by the upstream histidine kinase Bos1 and is not involved in dicarboximide- and phenylpyrrole-resistance. Fungal Genet Biol 45, 1062–1074 (2008).
Rodriguez, R. J., Low, C., Bottema, C. D. K. & Parks, L. W. Multiple functions for sterols in Saccharomyces cerevisiae. Biochim Biophys Acta 837, 336–343 (1985).
Fromont-Racine, M., Senger, B., Saveanu, C. & Fasiolo, F. Ribosome assembly in eukaryotes. Gene 313, 17–42 (2003).
Venema, J. & Tollervey, D. Ribosome synthesis in Saccharomyces cerevisiae. Annu Rev Genet 33, 261–311 (1999).
Kressler, D., Linder, P. & de, la, Cruz, J. Protein trans-acting factors involved in ribosome biogenesis in Saccharomyces cerevisiae. Mol Cell Biol 19, 7897–7912 (1999).
Fatica, A. & Tollervey, D. Making ribosomes. Curr Opin Cell Biol 14, 313–318 (2002).
Rasmussen, C. G. & Glass, N. L. Localization of RHO-4 indicates differential regulation of conidial versus vegetative septation in the filamentous fungus Neurospora crassa. Eukaryot Cell 6, 1097–1107 (2007).
Chen, C. & Dickman, M. B. CAMP blocks MAPK activation and sclerotial development via Rap-1 in a PKA-independent manner in Sclerotinia sclerotiorum. Mol Microbiol 55, 299–311 (2005).
An, B., Li, B., Qin, G. & Tian, S. Function of small GTPase Rho3 in regulating growth, conidiation and virulence of Botrytis cinerea. Fungal Genet Biol 75, 46–55 (2015).
Arbelet, D. et al. Disruption of the Bcchs3a chitin synthase gene in Botrytis cinerea is responsible for altered adhesion and overstimulation of host plant immunity. Mol. Plant Microbe. Interact 23, 1324–1334 (2010).
Soulie, M. C. et al. Botrytis cinerea virulence is drastically reduced after disruption of chitin synthase class III gene (Bcchs3a). Cell Microbiol 8, 1310–1321 (2006).
Tenberge, K. B., Tudzynski, B. & Tudzynski, P. Functional analysis of H2O2 generating systems in Botrytis cinerea: The major Cu-Znsuperoxide dismutase (BCSOD1) contributes to virulence on French bean, whereas a glucose oxidase (BCGOD1) is dispensable. Mol Plant Microbe Interact 5, 17–27 (2004).
Rolke, Y. et al. BcSAK1, a stressactivated mitogen-activated protein kinase, is involved in vegetative differentiation and pathogenicity in Botrytis cinerea. Eukaryot Cell 6, 211–221 (2007).
Yang, Q., Yan, L., Gu, Q. & Ma, Z. The mitogenactivated protein kinase kinase kinase BcOs4 is required for vegetative differentiation and pathogenicity in Botrytis cinerea. Appl Microbiol Biotechnol 96, 481–492 (2012).
Segmu ¨ller, N., Ellendorf, U., Tudzynski, B. & Tudzynski, P. BcSAK1, a stress activated mitogen-activated protein kinase, is involved in vegetative differ-entiation and pathogenicity in Botrytis cinerea. Eukaryot Cell 6, 21–221 (2007).
Viaud, M. et al. A class III histidine kinase acts as a novel virulence factor in Botrytis cinerea. Mol Plant Microbe Interact 19, 1042–1050 (2006).
Duan, Y., Ge, C., Liu, S., Wang, J. & Zhou, M. A two-component histidine kinase Shk1 controls stress response, sclerotial formation and fungicide resistance in Sclerotinia sclerotiorum. Mol Plant Pathol 14, 708–718 (2013).
Mullins, E. D. et al. Agrobacterium-mediated transformation of Fusarium oxysporum: an efficient tool for insertional mutagenesis and gene transfer. Phytopathology 91, 173–180 (2001).
Yu, J. H. et al. Double-joint PCR: a PCR-based molecular tool for gene manipulations in filamentous fungi. Fungal Genet Biol 41, 973–981 (2004).
Gronover, C. S., Kasulke, D., Tudzynski, P. & Tudzynski, B. The role of G protein alpha subunits in the infection process of the gray mold fungus Botrytis cinerea. Mol Plant Microbe Interact 14, 1293–1302 (2001).
McDonald, B. A. & Martinez, J. P. Restriction fragment length polymorphisms in Septoria tritici occur at high frequency. Curr Genet. 17, 133–138 (1990).
Yang, Q., Jiang, J., Mayr, C. & Hahn, M. & M, Z. Involvement of two type 2C protein phosphatases BcPtc1 and BcPtc3 in the regulation of multiple stress tolerance and virulence of Botrytis cinerea. Environ Microbiol 15, 2696–2711 (2013).
Zheng, Z. et al. FgFim, a key protein regulating resistance to the fungicide JS399-19, asexual and sexual development, stress responses and virulence in Fusarium graminearum. Mol Plant Pathol 15, 488–499 (2014).
Wang, Y., Duan Y. B., Wang, J. X. & Zhou, M. G. A new point mutation in the iron–sulfur subunit of succinate dehydrogenase confers resistance to boscalid in Sclerotinia sclerotiorum. Mol Plant Pathol 16, 653–661 (2015).
Acknowledgements
This work was supported by the National Natural Science Foundation of China (31171880), Special Fund for Agro-scientific Research in the Public Interest (201303023) and Agricultural Science and Technology Innovation Fund Project of Jiangsu province, China (CX (14) 2054).
Author information
Authors and Affiliations
Contributions
C.C. and W.S. designed the study. W.S., Y.Z., J.W. and C.L. performed the experiments. W.S. and Y.Z. analyzed the data. W.S. wrote the manuscript with assistance from other authors. All authors read and approved the final manuscript.
Ethics declarations
Competing interests
The authors declare no competing financial interests.
Electronic supplementary material
Rights and permissions
This work is licensed under a Creative Commons Attribution 4.0 International License. The images or other third party material in this article are included in the article’s Creative Commons license, unless indicated otherwise in the credit line; if the material is not included under the Creative Commons license, users will need to obtain permission from the license holder to reproduce the material. To view a copy of this license, visit http://creativecommons.org/licenses/by/4.0/
About this article
Cite this article
Shao, W., Zhang, Y., Wang, J. et al. BcMtg2 is required for multiple stress tolerance, vegetative development and virulence in Botrytis cinerea. Sci Rep 6, 28673 (2016). https://doi.org/10.1038/srep28673
Received:
Accepted:
Published:
DOI: https://doi.org/10.1038/srep28673
This article is cited by
-
Insights into the molecular interplay of virulence factors in Botrytis cinerea
Australasian Plant Pathology (2017)